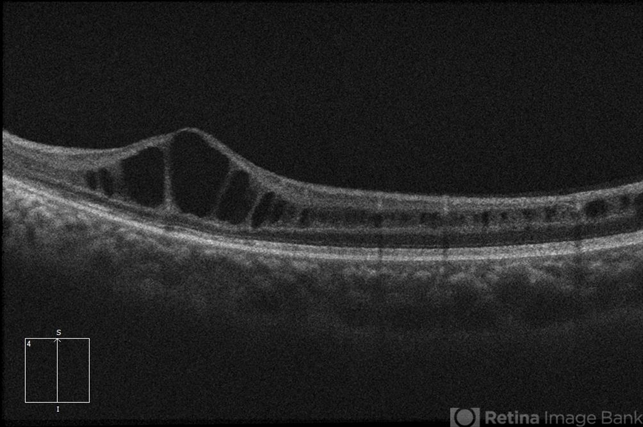

-
 By Aaron P. Appiah, MD
By Aaron P. Appiah, MD
Capital Eye Consultants
Co-author(s): Hosam Attia, M.D. - Uploaded on May 9, 2018.
- Last modified by Caroline Bozell on May 10, 2018.
- Rating
- Appears in
- Miscellaneous
- Condition/keywords
- retinoschisis
- Imaging device
-
Optical coherence tomography system
Zeiss Cirrus 5000 - Description
- 21-year-old male with congenital retinoschisis with bilateral macular involvement and large inner retinal hole OD.

Initializing download.
Initializing download.







---thumb.jpg/image-square;max$79,0.ImageHandler)


